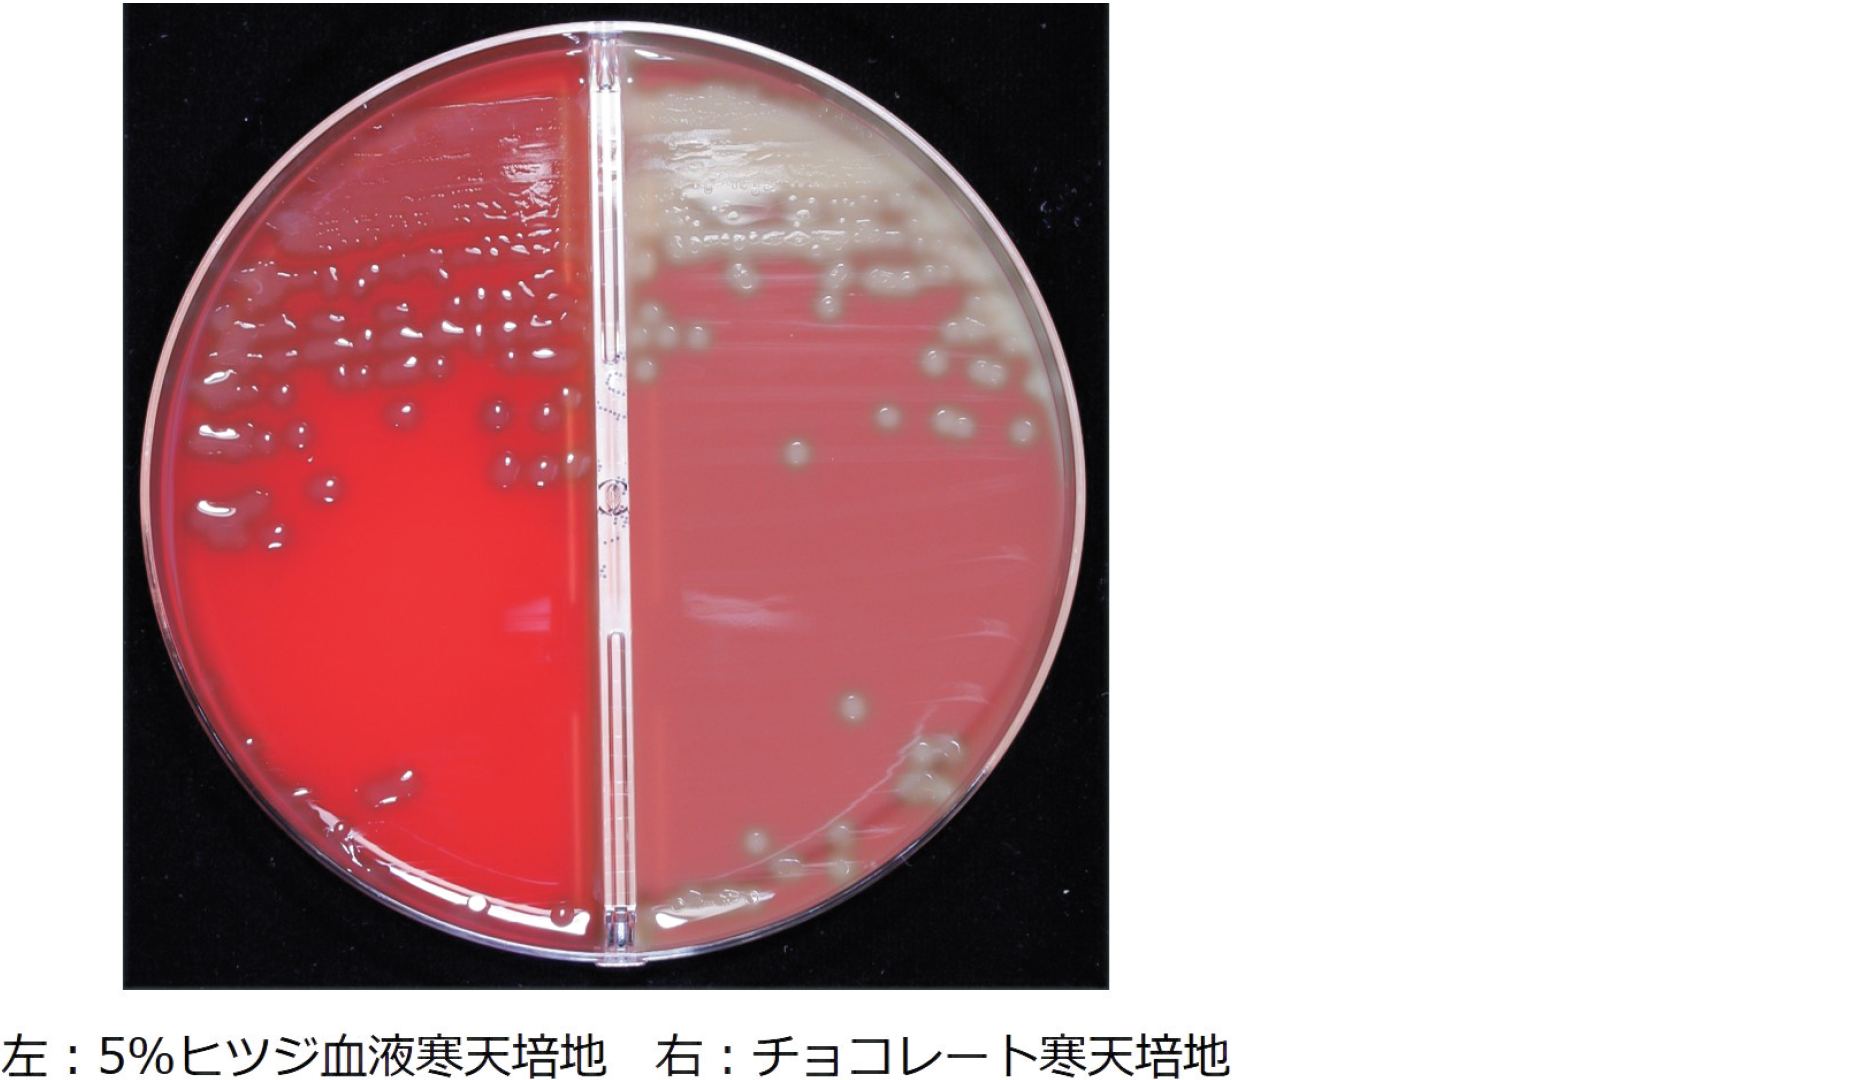

髄膜炎が疑われる患者の髄液を5%ヒツジ血液寒天培地(左)とチョコレート寒天培地(右)の分画培地で35℃,24 時間,炭酸ガス培養した写真を示す。髄液のGram染色では,多数の好中球と共にGram陽性球菌が認められた。分離菌はBTB乳糖寒天培地に発育せず,カタラーゼ試験陰性,オプトヒンに感性を示した。
推定される菌種はどれか。
- 1. Listeria monocytogenes
- 2. Neisseria meningitidis
- 3. Staphylococcus aureus
- 4. Streptococcus agalactiae
- 5. Streptococcus pneumoniae